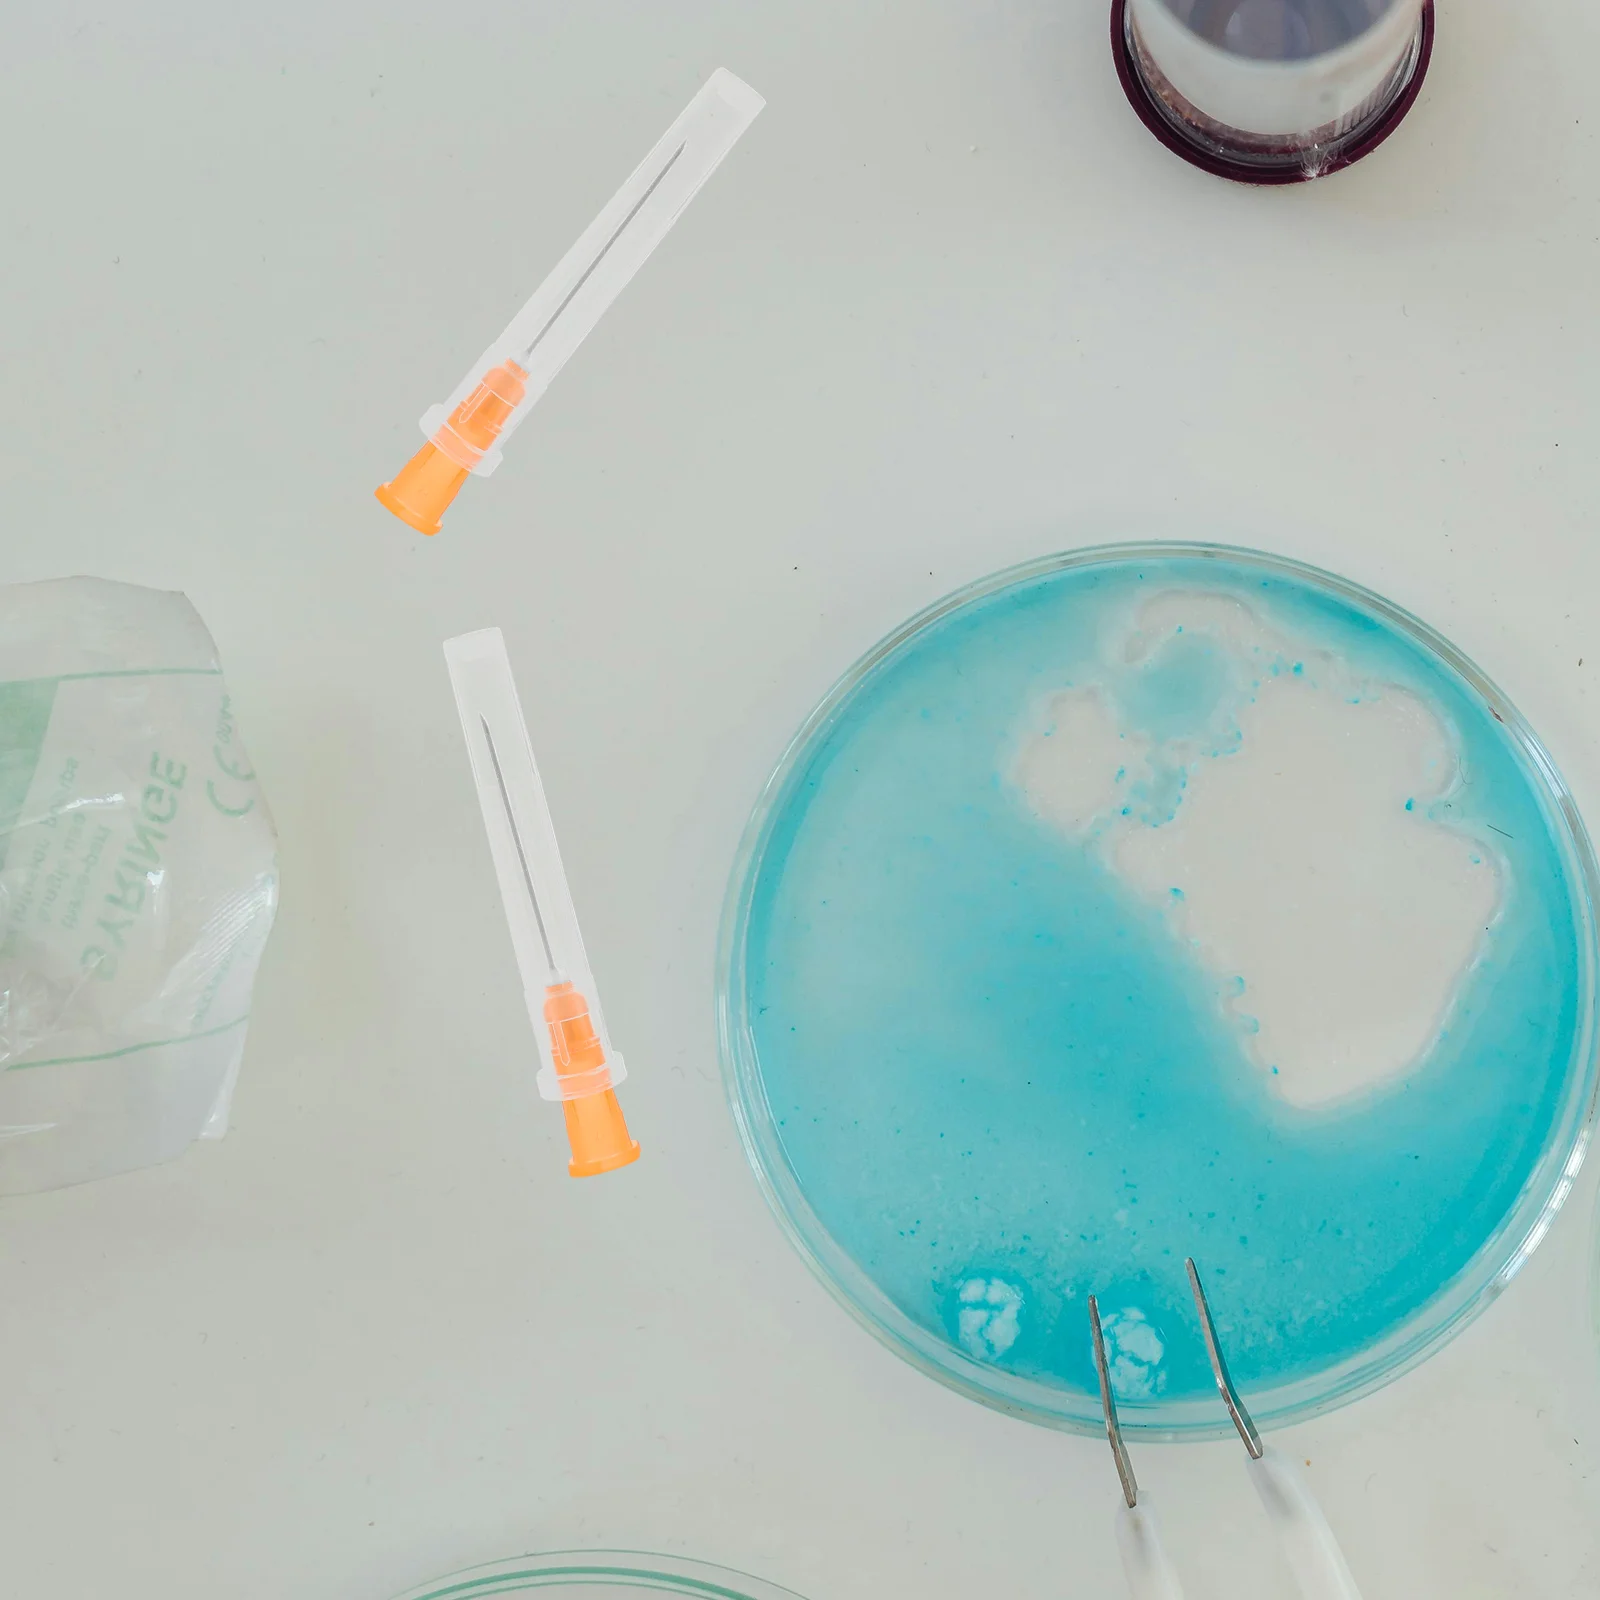

Набор для дозирования игл в шприце, из нержавеющей стали, 25 г, 100 шт.
Price history chart & currency exchange rate
Customers also viewed

$46.80
Hot Selling Italian Gold Plated Jewelry Set Brazil Gold Lady Necklace Ring Earrings Wedding Jewelry H0061
aliexpress.com
$69.38
Simple Wedding Dress Appliques A-line Off the Shoulder Beach Elegant Fashion Sweetheart Robe De Mariee Excellent For Women
aliexpress.com
$11.57
Washed Cotton Trimmings Shorts Summer Fashion Unisex Brief Straight Shorts Boys and Girls Kids Bottoms Korean Casual Pants Child
aliexpress.com
$380.00
Tool shank for external internal circle turning threading lathe cutter turning tool
aliexpress.com
$16.63
Size 16-26 Kids Fashion Princess Sandals Girls Soft Bottom Beach Sandal Children Casual Anti-slip Shoes Baby Toddler Footwear
aliexpress.com
$3.60
COLOMBIA T Shirt Name Number Col T-shirt Photo 0 Clothes Print Diy Free Custom Made Tshirts Respirant 3D 4XL 5XL Big Size 6XL
aliexpress.com
$3.40
Disney Cute Mickey Mouse Figure Toy Toothpicks bucket Kitchen Decoration Storage Bottle Container Figure Toy
aliexpress.com
$18.92
HIR2 Car Headlight H4 LED 110W H7 H16 JP canbus H9 H8 H11 9005 9006 55W 20000lm 6500K car Styling Auto Headlamp Fog Light Bulbs
aliexpress.com
$52.51
Cooler Master MM711 Lite RGB Backlight Gaming Mouse Lightweight Honeycomb Shell For Computer PC Laptop Gamer Complete Mause
aliexpress.com
$3.08
10pcs Lenses Case Holder Storage Box Container for Home and Travel (Random Color)
aliexpress.com
$48.46
IP68 Waterproof Smart Watch Women Lovely Bracelet Heart Rate Monitor Sleep Monitoring Smartwatch Connect IOS Android KW10 band
aliexpress.com
$3.96
2 Roll Round Self Adhesive Planet Sticker Creative Space Sticker Roll Decoration for Envelope Planner Scrapbook Sticker Decals
aliexpress.com
$1.70
1 Pair Exercise Bike Belts Bicycle Pedal Straps Generic For Most Schwinn More Stationary Cycling Fix Bands Tape Fitness
aliexpress.com
$235.39
Ноутбук Dell Inspiron 3552 Pentium N3710, 4Gb, 500Gb, DVD-RW, Intel HD Graphics, 15.6", HD (1366x768), Linux, black, WiFi, BT, Cam, 2700mAh
gogol.ru
$47.12
Fashion Print Pajamas Set Summer Sleepwear For Women Casual Home Wear Ladies Night Big Size Pijamas Pyjamas
aliexpress.com
$24.75
Glass Vase Potted Decoration Nordic Decorative Vase Hydroponic Terrarium Arrangement Container Flower Table Vase Home Decor
aliexpress.com
$48.19
For Yamaha TENERE 700 TRACER 900GT 19-2020 Motorcycle Accessories Brake Handle Adjustable Brake Clutch Levers Handbar End Grips
aliexpress.com
$14.90
Car DVR Dash Camera HD 1080P Driving Recorder Video Night Vision Loop Recording Wide Angle Motion Detection Dashcam
aliexpress.com
$18.57
teehub men's new fashion eva ukiyo-e design short sleeve t-shirt cool printed hipster tee shirts
dhgate.com
$18.57
masters of the universe - skeletor graphic custom funny tshirt skeletor masters of the universe motu master universe
dhgate.com
$18.57
urban style #survival #outdoor #nature t shirt men customized cotton round neck letter fitness building spring autumn family shirt
dhgate.com
$18.57
veteran long hours may cause binge drinking t shirt men print 100% cotton s-xxxl male cute building summer family shirt
dhgate.com
$18.57
for fox sakes cute cunning animal funny gif t shirt men printing cotton o neck letter fit basic spring autumn vintage shirt
dhgate.com
$18.57
mononoke spirit princess mononoke t shirt cotton short sleeve custom brand clothing 2019 new team xxxl t shirts
dhgate.com
$13.64
women leather belts fashion casual woman brand belts layer leather pin buckle female luxury, Black;brown
dhgate.com
$42.47
fitness supplies 1pcs 3colors hand boxing target pads focus pad punch training glove karate muay thai mma kick pads fight fitness equipment
dhgate.com
$1.52
smart watch silicone protective case tpe material cover replacement applicable for garmin forerunner235 735xt universal wholesale cheap
dhgate.com
$38.16
striped vestidos plus size autumn long maxi dress fall dresses for women ladies sukienki vestido longo robe longue femme elbise
dhgate.com
$8.80
dhl acrylic tumblers with lids and straws skinny 16oz double wall clear plastic tumblers with straw
dhgate.com
$13.58
cat lisa painting gift t shirt men fitness cotton o neck costume fitness basic spring letter shirt
dhgate.com